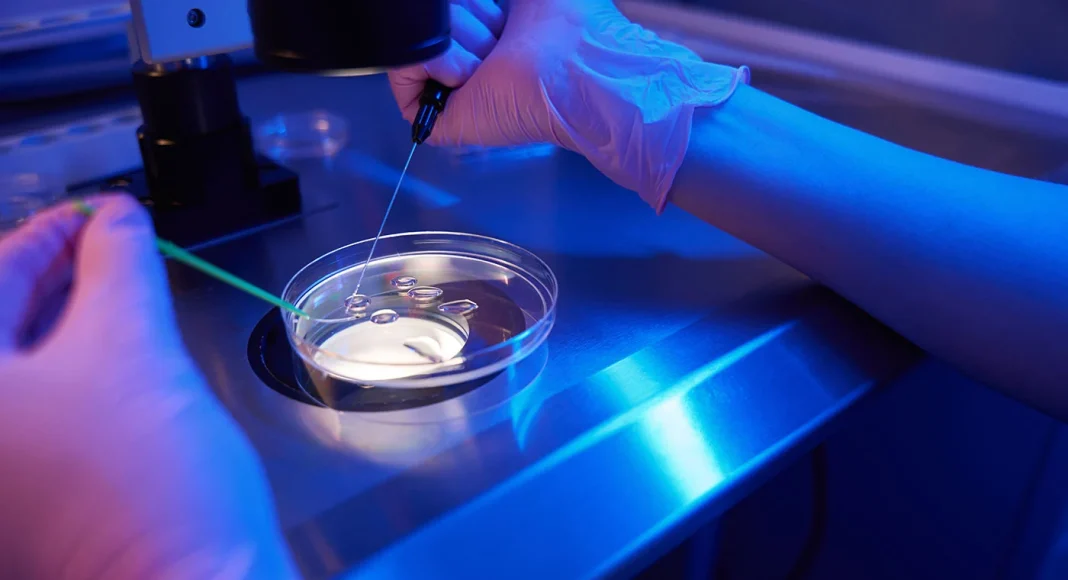

Într-o mișcare strategică menită să combată declinul demografic și să sprijine familiile din România, Guvernul a aprobat joi continuarea și extinderea programului de fertilizare in vitro (FIV) pentru perioada 2026-2030. Anunțul, făcut de purtătoarea de cuvânt a Executivului, Ioana Dogioiu, vine ca o gură de oxigen pentru mii de persoane care se luptă cu infertilitatea.
Ce presupune ajutorul financiar?Sprijinul total oferit de stat este de 15.000 de lei pentru fiecare beneficiar eligibil. Această sumă nu este acordată direct în bani, ci sub formă de două vouchere digitale, menite să acopere etapele esențiale ale tratamentului:Voucher pentru medicamente: În valoare de 5.000 de lei, destinat tratamentului hormonal și medicației specifice necesare pregătirii procedurii.
Voucher pentru proceduri medicale: În valoare de 10.000 de lei, pentru acoperirea costurilor tehnice ale fertilizării în vitro în clinicile acreditate.Cine sunt beneficiarii eligibili?Programul este conceput să fie incluziv, adresându-se mai multor categorii de cetățeni care se confruntă cu probleme medicale de reproducere:
Cuplurile infertile: Indiferent dacă sunt căsătorite sau trăiesc în uniune consensuală (concubinaj).
Femeile singure: Care doresc să devină mame și au diagnostic de infertilitate.Criterii de vârstă și sănătatePentru a accesa aceste vouchere, solicitanții trebuie să îndeplinească următoarele condiții:Vârsta: Persoanele de sex feminin trebuie să aibă vârsta cuprinsă între 24 și 45 de ani (la momentul depunerii dosarului).Diagnostic: Existența unei dovezi medicale privind infertilitatea, eliberată de un medic specialist în obstetrică-ginecologie cu supraspecializare în Reproducere Umană Asistată.
De ce este necesar acest program?Infertilitatea este recunoscută oficial ca o problemă de sănătate publică, afectând aproximativ 10-15% dintre cuplurile de vârstă reproductivă din România. Costurile ridicate ale procedurilor private fac adesea imposibil accesul la tratament pentru familiile cu venituri medii.